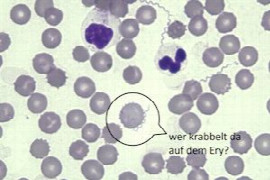

Nikola Katic
DVM, DipECVS

Nikola Katic
DVM, DipECVS
Dr Katic is a diplomate of European College of Veterinary Surgeons. He is a consummate small animal surgeon with special emphasis on minimal invasive surgery. He graduated from University of Veterinary Medicine Vienna in 2002 where he subsequently completed his doctoral thesis and the ECVS residency program. He served as a senior lecturer in small animal surgery at the University of Veterinary Medicine Vienna before he changed into private practice. He currently holds the position of chief of surgery at AniCura Tierklinik Hollabrunn, which is one of the busiest referral clinics in Austria. He is the first author and co-author of various publications in the field of small animal surgery and regularly takes part as speaker and instructor on different national and international conferences and courses. Dr Katic is husband and father of two boys.
Webinare

Nikola Pantchev
DVM, FTA für Parasitologie

Nikola Pantchev
DVM, FTA für Parasitologie
Studium der Veterinärmedizin in Gießen und Assistenzzeit am Institut für Parasitologie der Justus-Liebig-Universität Gießen, mit Promotion über Human- und Nager-pathogene Filarien. In der Folge Tätigkeit in der Pharmaindustrie (Intervet/MSD) mit Schwerpunkt Entwicklung neuer Ektoparasitika gegen Zecken und Flöhe für Hund und Katze. Fachtierarzt für Parasitologie mit besonderen Interessen für Infektionskrankheiten bei Klein- und Heimtieren; Koautor von mehreren Fachbüchern und zahlreicher wissenschaftlicher Publikationen.
Dr. Nikola Pantchev arbeitete zuletzt als Leiter der Bereiche Serologie und Parasitologie bei IDEXX Laboratories in Ludwigsburg. Seit 2015 verstärkt er als weiterer Key Account Manager mit Schwerpunkt Infektionskrankheiten das IDEXX-Team. Er hält Seminare u.a. zu Vektor-übertragenen Erkrankungen ab und steht den Kunden von IDEXX Labortories sowie Universitäten vor Ort als Ansprechpartner in Sachen Laboranalysen und Schnelltests zur Verfügung.
Webinare

Nina Fischer
DVM, Dipl. ECVD

Nina Fischer
DVM, Dipl. ECVD
Nach dem Veterinärstudium an der Universität in München verbrachte Nina Fischer ein Jahr in den USA, wo sie an der North Carolina State Universität im Bereich der Dermatologie/ Immunologie für Ihre Doktorarbeit geforscht hat. Nach einem Jahr Allgemeinpraxis hat sie ein Internship am Tierspital Zürich und anschliessend ihre Residency in der Dermatologie bei Herrn Prof. Favrot absolviert.
Seit 2014 arbeitet sie als Oberärztin in der Abteilung für Dermatologie und ist neben der Klinik auch in die Lehre und Forschung involviert. Ihr Forschungsschwerpunkt liegt dabei im Bereich der caninen und felinen Allergologie, ihre Habilitation beschäftigt sich insbesondere mit der Allergenspezifischen Immuntherapie.
Webinare

Nina Gasparik-Küls
DVM, Dipl. ECVAA

Nina Gasparik-Küls
DVM, Dipl. ECVAA
Dr. Nina Gasparik-Küls studierte Veterinärmedizin an der JLU Gießen. Nach ihrer Approbation verbrachte sie zwei Jahre in einer Gemischtpraxis in Kanada, bevor sie für einen Internship an der Pferdeklinik der VMU Wien nach Europa zurückkehrte. Während des Internships entdeckte sie ihre Begeisterung für Anästhesie und begann eine Residency am RDSVS, Edinburgh, die sie erfolgreich mit dem Diplomate des ECVAA abschloss und nach Wien zurückkehrte. Nach knapp 10 Jahren als an der Veterinärmedizinischen Universität Wien übernahm sie 2023 die Leitung der Anästhesie im Vetklinikum Wien.
Webinare

Nina Glos
DVM, Dipl ECVD (Dermatology), Fachtierärztin für Dermatologie der Kleintiere

Nina Glos
DVM, Dipl ECVD (Dermatology), Fachtierärztin für Dermatologie der Kleintiere
1998-2000: Ausbildung zur Tierarzthelferin
2000 - 2006: Studium der Tiermedizin an der Medizinischen Kleintierklinik der LMU München
2006 - 2007: Wissenschaftliche Mitarbeiterin an der Medizinischen Kleintierklinik der LMU München
und Doktorarbeit über das Thema Futtermittel bei atopischen Hunden
2007 - 2012: Residency des European College of Veterinary Dermatology bei Dr. Sonya Bettenay in der Klinik Haas & Link
2013: Juli: Prüfung zum Diplomate des European Colleges of Veterinary Dermatology
Oktober: Prüfung zur Fachtierärztin für Dermatologie der Kleintiere
Seit 2013: Selbstständig als Veterinär-Dermatologin in Germering bei München
aktuell: Selbstständig als Veterinär-Dermatologin in Germering bei München, in Starnberg, in Gessertshausen und als Expertin für SYNLAB.vet
-bis 2022 Präsidentin der Deutschen Gesellschaft für Veterinärdermatologie
-Präsidentin des European Colleges of Veterinary Dermatology
Webinare

Nina Keyserlingk
Prof., DVM

Nina Keyserlingk
Prof., DVM
Dr. Marina (Nina) von Keyserlingk is a Professor and Natural Sciences and Engineering Research Council of Canada Industrial Research Chair in Animal Welfare at the University of British Columbia. Her interdisciplinary approach has focused on identifying measures and ways of improving the lives of animals under our care. Areas where her work have impacted animal care on farms include feed bunk management, stall design, lameness, transition cow health, calf feeding and management. She is also among the first in her field to combine experimental and qualitative methods when addressing animal welfare issues. She has received numerous awards, including the 2018 Hans Sigrist Foundation Prize, administered by the University of Bern, Switzerland, for her outstanding achievements as an international leader working in the field of sustainable food animal production. She was also awarded the American Dairy Science Association Extension Award in 2018, the Award for outstanding contributions to the field of ruminant well-being by the World Buiatrics Association in 2016 and the American Dairy Science Association Award for Excellence in Dairy Science in 2013.
Webinare

Noam Pik
DVM, BVSc, BMVS, MBA, MACVS

Noam Pik
DVM, BVSc, BMVS, MBA, MACVS
Graduated as a veterinary surgeon from Murdoch University, WA. Australia in 1996 after completing an independent research project on the effects of Progesterone on exercise physiology in racing mares. Noam gained further qualification in business management and marketing and has lectured at the Koret School of Veterinary Medicine, the Hebrew University of Jerusalem, Israel before returning to Australia in 2001 and establishing the South Eastern Animal Emergency Centre in 2003 and the Veterinary Referral Hospital in 2005. He is a member of the ANZCVS in the chapter of Emergency and Critical Care. In 2008 Noam established the Australian Specialized Veterinary Pathology (ASAP) Laboratory (now part of Primary Healthcare) and Orivet Genetics Laboratory in 2010. The latter is focused on delivering personalized medicine and genetic solutions to veterinarians, pet owners and breeders of companion animals. He also helped build the Veterinary Genetics Assurance (VGA) program to breeders in Australia and around the world. Noam is a strategic consultant to Biotempus Ltd an Australian biotechnology company focusing on cancer and immune mediated diseases in both human and animals. Noam has a keen interest in delivering high quality clinically-oriented services to the veterinary community and especially in the fields of pathology, genetics, immunology and applied bioinformatics.
Webinare

Norbert Langen
DVM, FTA für Chirurgie der Kleintiere

Norbert Langen
DVM, FTA für Chirurgie der Kleintiere
Studium Veterinärmedizin an der JLU Gießen: Approbation 2007
Dissertation 2014 : Magnetresonanztomographische Gehirnmorphologie des Schafes
Fachtierarzt für Chirurgie der Kleintiere 2017
Zusatzbezeichnung Neurologie beim Kleintier 2019
Zur Zeit leitender Oberarzt der Klinik für Kleintiere der Justus- Liebig-Universität Gießen - Abteilung Chirurgie/Orthopädie
Webinare

Norman Johnston
FRCVS, RCVS

Norman Johnston
FRCVS, RCVS
Norman Johnston is a graduate of the Royal (Dick) School of Veterinary Studies, University of Edinburgh. He is clinical director of DentalVets - a referral only dental and oral surgical practice near Edinburgh in Scotland. Before embarking on a specialist career, he spent 21 years in general practice in Edinburgh. His qualifications are unique as he is a current diplomate of both the American and European Veterinary Dental Colleges, a fellow of the Academy of Veterinary Dentistry and has been a registered RCVS Specialist in Veterinary Dentistry since 2002. He is a past president of both the European Veterinary Dental College, the British Veterinary Dental Association and a past board member of many veterinary dental organisations world-wide. He is also a past chairman and director of VET Trust, an educational veterinary charity based in Scotland. In 1997 he received the Simon Award from the British Small Animal Veterinary Association for outstanding contributions in the field of veterinary surgery and was made a Fellow of the Royal College of Veterinary Surgeons in 2016 for meritorious contributions to clinical practice.
Webinare

Odile Sénécat
DVM, PhD

Odile Sénécat
DVM, PhD
Diplômée de l’école vétérinaire de Nantes en 1988, Pratique libérale en clientèle canine pendant 2 ans, Assistante au service de médecine interne de l’école vétérinaire de Nantes entre 1991 et 1996, Obtention d’un PhD en immunoendocrinologie cellulaire et moléculaire en 1996 (« essais de modulation du diabète de type 1 chez la souris Non Obese Diabetic par l’administration de substances insulinosécrétrices ou de ciclosporine A », Maître de conférences en médecine interne des Animaux de Compagnie depuis 1996. Responsable du service clinique de médecine interne à Oniris, responsable du secteur d’approfondissement (5ème et dernière année d’étude) à Oniris. Consultations spécialisées de médecine interne et d’endocrinologie à Oniris. Membre de l’unité de recherche en Immuno-Endocrinologie Cellulaire (IECM).
Nombreux cours (formation initiale à Oniris, internat, CEAV de médecine interne), publications, conférences dans le domaine de l’endocrinologie.
Webinare

Oliver Harms
DVM

Oliver Harms
DVM
- 1998-2004: Studium TiHo Hannover
- 2004-2009: wiss. Mitarbeiter Klinik für Kleintiere TiHo Hannover
- 2009-2014: Tierklinik Lüneburg
- seit 2015: Klinik für Kleintiere TiHo Hannover
Webinare

Olivier Levionnois
DVM, PhD, Dipl. ECVAA

Olivier Levionnois
DVM, PhD, Dipl. ECVAA
Abschluss des Tiermedizinstudiums an der Ecole Nationale Vétérinaire de Nantes (Frankreich, 2001) und Internship in der Pferdemedizin in Montreal (Canada, 2001-02). Dissertation in der Anästhesie über Opioiden bei Pferden (DMV, Nantes 2002 ; Dr. med. vet., Bern 2006). Resident für Anästhesie und Schmerztherapie (ECVAA) am Tierspital der Vetsuisse Fakultät, Bern mit Abschlussdiplom in 2007 (DECVAA). In 2008 und 2009, klinischer Assistent in der Abteilung Anästhesie und Schmerztherapie an der Vetsuisse Fakultät Bern und PhD-Student (2008-2011) an der Graduate School for Cellular and Biomedical Sciences der Universität Bern. In 2010 und 2011, Oberassistent in der Abteilung Anästhesie und Schmerztherapie an der Vetsuisse Fakultät Bern. In 2012, Postdoctoral wissenschaftlicher Mitarbeiter an der Veterinärmedizinische Hochschule der Universität Oslo, Norwegen. Seit 2013, Oberassistent in der Abteilung Anästhesie und Schmerztherapie an der Vetsuisse Fakultät Bern.
Webinare

Otto Fischer
Univ. Lekt., DVM

Otto Fischer
Univ. Lekt., DVM
Curriculum
1978 - 1985: Studium der Veterinärmedizin in Wien (Österreich)
1985 - 1987: Dissertation am Institut für Ernährung der Vetmed Uni Wien, Promotion
1985 - 1989: Assistent in einer Gemischtpraxis in Niederösterreich
1989: Mitbegründer Tierspital Korneuburg, seit 2016 AniCura Tierklinik Korneuburg
seit 1995: Fachtierarzt für Kleintiere; Dermatologischer Konsiliarservice für TierärzteInnen
seit 1995: Universitätslektor für Dermatologie an der Vetmeduni Vienna; Organisation von Seminaren und Vortragender auf dem Gebiet der Dermatologie und Zytologie
2004: Local Organizer 5th World Congress of Veterinary Dermatology in Wien
seit 2004: Tutor der ESAVS Dermatologiekurse in Europa, China und Indonesien
seit 2005: Fachtierarzt für Dermatologie
2014: Local Organizer 27th ESVD Congress Salzburg
2017: Gründungsmitglied ÖGVD Österreichische Gesellschaft für Veterinärdermatologie
Mitglied der ESVD, DGVD, OEGVD und VÖK
Privates
Dr. Fischer hat eine Tochter. In seiner Freizeit ist er gerne in der Natur und auch in Konzertsälen unterwegs. Und er engagiert sich seit 2007 für Menschen und Tiere in Ruanda (www.future4kids.at und www.nvvh.rw).
Webinare

Paige Taylor
RVN

Paige Taylor
RVN
I started my career 10 years as a wildlife and shelter nurse before moving into specialty as a surgery nurse at Brisbane Veterinary Specialist Centre 5 years ago. I have been Primary Surgery Nurse at BVSC for the last 2 years and love all things anesthesia but have a keen interest in cat anesthesia and neurosurgery, especially brains. I have nursed many a spinal patient through surgery and recovery and love watching their progress. When I am not at work, I am at the beach with my moodle Riley or on the couch with my DSH Lucy, Norwegian Forest Cat Lilly and Bourkes parrot Frenchie geeking out over Batman comics and anesthesia webinars.
Webinare

Pascal Prélaud
DVM

Pascal Prélaud
DVM
Spécialiste en dermatologie vétérinaire.
Diplômé du Collège Européen de Dermatologie Vétérinaire (ECVD)
.
Responsable du département d'otologie du CVS Advetia à Paris.